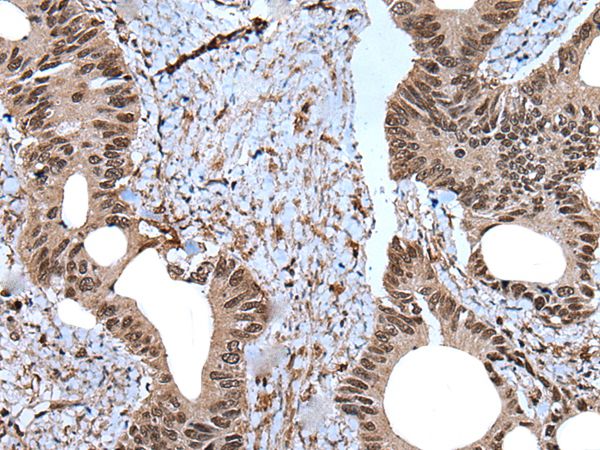
Anti-ZNF787 Antibody

Immunohistochemical staining of human rectum shows moderate nuclear positivity in glandular cells.
Anti-ZNF787 Antibody
HPA035140
ApplicationsWestern Blot, ChIP Chromatin ImmunoPrecipitation, ImmunoCytoChemistry, ImmunoHistoChemistry
Product group Antibodies
ReactivityHuman
TargetZNF787
Overview
- SupplierAtlas Antibodies
- Product NameAnti-ZNF787 Antibody
- Delivery Days Customer4
- ApplicationsWestern Blot, ChIP Chromatin ImmunoPrecipitation, ImmunoCytoChemistry, ImmunoHistoChemistry
- CertificationResearch Use Only
- ClonalityPolyclonal
- ConjugateUnconjugated
- Gene ID126208
- Target nameZNF787
- Target descriptionzinc finger protein 787
- Target synonymsTIP20, zinc finger protein 787, TTF-I-interacting peptide 20, transcription termination factor I interacting peptide 20
- HostRabbit
- IsotypeIgG
- Scientific DescriptionRecombinant Protein Epitope Signature Tag (PrEST) antigen sequence
- ReactivityHuman
- Storage Instruction-20°C,2°C to 8°C
- UNSPSC41116161
![Lane 1: Marker [kDa] 230, 130, 95, 72, 56, 36, 28, 17, 11. Lane 2: Human cell line RT-4. Lane 3: Human cell line U-251MG sp Lane 1: Marker [kDa] 230, 130, 95, 72, 56, 36, 28, 17, 11. Lane 2: Human cell line RT-4. Lane 3: Human cell line U-251MG sp](https://atlasantibodies.s3.amazonaws.com/images/wb/hpa035140-wb-1.jpg)